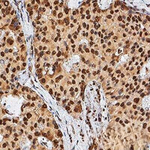
TERT Antibody in Immunohistochemistry (Paraffin) (IHC (P))

Search
Invitrogen
TERT Monoclonal Antibody (2D8)
{{$productOrderCtrl.translations['antibody.pdp.commerceCard.promotion.promotions']}}
{{$productOrderCtrl.translations['antibody.pdp.commerceCard.promotion.viewpromo']}}
{{$productOrderCtrl.translations['antibody.pdp.commerceCard.promotion.promocode']}}: {{promo.promoCode}} {{promo.promoTitle}} {{promo.promoDescription}}. {{$productOrderCtrl.translations['antibody.pdp.commerceCard.promotion.learnmore']}}
图: 1 / 6
TERT Antibody (MA5-16033) in ICC/IF

产品信息
MA5-16033
种属反应
已发表种属
宿主/亚型
分类
类型
克隆号
抗原
偶联物
形式
浓度
保存液
内含物
保存条件
运输条件
RRID
产品详细信息
Suggested positive control: 293T whole cell lysates, HeLa whole cell lysates, antigen standard for TERT (transient overexpression lysate).
靶标信息
Telomerase is a ribonucleoprotein polymerase that maintains telomere ends by addition of the telomere repeat TTAGGG. The enzyme consists of a protein component with reverse transcriptase activity, encoded by this gene, and an RNA component which serves as a template for the telomere repeat. Telomerase expression plays a role in cellular senescence, as it is normally repressed in postnatal somatic cells resulting in progressive shortening of telomeres. Deregulation of telomerase expression in somatic cells may be involved in oncogenesis. Studies in mouse suggest that telomerase also participates in chromosomal repair, since de novo synthesis of telomere repeats may occur at double-stranded breaks. Alternatively spliced variants encoding different isoforms of telomerase reverse transcriptase (TERT) have been identified; the full-length sequence of some variants has not been determined. Alternative splicing at this locus is thought to be one mechanism of regulation of telomerase activity.
仅用于科研。不用于诊断过程。未经明确授权不得转售。
生物信息学
蛋白别名: HEST2; hTERT; Telomerase catalytic subunit; Telomerase reverse transcriptase; Telomerase-associated protein 2; TP2; unnamed protein product
基因别名: CMM9; DKCA2; DKCB4; EST2; hEST2; hTRT; PFBMFT1; TCS1; TERT; TP2; TRT
UniProt ID: (Human) O14746
Entrez Gene ID: (Human) 7015




